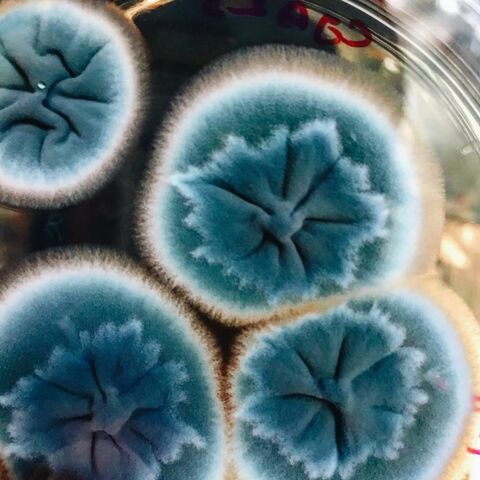
Hongos resistentes a Fungicidas

-
Primero en estudiar y escribir acerca de enfermedades de árboles cereales y leguminosos. Basó sus estudios en observaciones y especulaciones sin experimentación
-
Preparó una infusión de pimienta proveniente de traída por los navegantes de Oriente y agua de lluvia, la dejó reposar y luego de unos días la observó con un microscopio construido por él mismo. Observó que en una sola gota de aquella sustancia se movían muchísimas criaturas pequeñas, a las que bautizó como animáculos.
-
Pier Antonio Michelli analizó que al tomar el polvo producido por hongos y llevarlos a otro medio favorable de crecimiento estos daban lugar a la proliferación del mismo hongo, concluyendo que eran las semillas de los hongos.
-
El añublo del trigo o carbón cubierto es una enfermedad contagiosa en plantas. Mathieu Tillet aplicó distintos tratamientos a las semillas y observó que la presencia de la enfermedad disminuía.
-
Isaac Prevost mostró que el "carbón" que cubre al trigo es ocasionado por un hongo. Rechazó la generación espontánea.
-
Phytophthora infestans, causante de la enfermedad del Tizón Tardío causó causó graves daños alimenticios en Irlanda, muchas personas murieron del hambre por la dependencia de papa del país
-
Considerado el Padre de la Fitopatoogía, se dedicó a estudiar la morfología de los hongos, encontrando que presentan distintas etapas en su ciclo de vida de las que antes se diferenciaban en especies. Introduce el término Mixomicetes para englobar los animales inferiores y los mixomicetes, de los que explica tienen una etapa de su ciclo vital, (etapa plasmodial) donde no toman veramente de forma, como sustancia.
-
Fue Anton de Bary quien demostró luego de realizar varios experimentos que la enfermedad del Tizón Tardío de la papa era causada por Phytophthora infestans, un hongo patógeno
-
La enfermedad del ántrax afectaba principalmente a animales y en menor cantidad a humanos. Fueron Louis Pasteur y Robert Koch quienes demostraron que era causada por una bacteria
-
El asistente de Robert Koch, Julius Richard Petri, diseñó unas placas que hacían más práctico el cultivo y estudio de microorganismos
-
Brefeld contribuyó mucho a la fitopatología al desarrollar técnicas de cultivo de microorganismos en cultivos puros. Posteriormente las técnicas fueron perfeccionadas por Koch, Petri y otros.
-
Caldo Bordelés fue el nombre de la mezcla de cal y sulfato de cobre creada por Pierre-Marie-Alexis Millardet para rociar los viñedos para evitar rapiña y controlar mildiu de la vid.
-
Anton De Bary trabajó con el hongo Sclerolinia. Concluyó que el hongo patógeno producía enzimas y toxinas que lo ayudaban a degradar y matar a las células infectadas de la planta.
-
Se identificó que la enfermedad del mosaico del tabaco podía ser transmitido si se inoculaba con jugo de una planta enferma
-
Robert Koch publica una lista de requerimientos para la validación de la presencia de un virus y una enfermedad.
-
Se realizó un ensayo en el que filtraban las bacterias del jugo de un ejemplar infectado, resultando en que el jugo seguía siendo infectivo. Concluyeron que no era una bacteria el agente infeccioso de tal enfermedad.
-
Fischer se oponía a las afirmaciones de Smtih, quien decía que las bacterias tenían carácter fitopatogénico. Fischer sostenía que las bacterías no encontraban nutrientes en los espacios intercelulares y que se nutrían de los residuos de las lesiones que los hongos hacían en las células vegetales
-
Martinus Willem Beijerinck determinó que la enfermedad del mosaico del tabaco no era causada por una bacteria, sino por un agente virulento, que denominó como contagium vivium fluidum
-
Jugó un papel importante en la demostración de que las bacterias podrían causar enfermedades de las plantas. Publicó en una serie de tres volúmenes sus trabajos de bacterias causantes de marchitez en plantas y de que son las causantes de provocar enfermedades en ellas.
También estudió la enfermedad del azote cocotero en las Antillas y en Cuba, en donde publicó sus trabajos en la Reunión de la Sociedad de Morfología y Fisiología Occidental y en la Revista Science -
A inicios del siglo XX comenzaron los estudios de hongos en Rusia, pero fue hasta en 1917 (luego de la Revolución Socialista) que se logró desarrollar ampliamente
-
Samuel L. Tisdale desarrolló un fungicida de ditiocarbamatos (tuíram), del que posteriormente desarrolló otros más como el ferbam, zineb y maneb.
-
Primer uso de antibióticos para el control y tratamiento de enfermedades en plantas
-
Se encontraron cepas de bacterias que presentaban resistencia a la aplicación de antibióticos
-
Se encontraron cepas de hongos que eran capaces de resistir al efecto de sustancias fungicidas
-
Fueron von Schmeling y Kulka quienes introdujeron la carboxina como primer fungicida de carácter sistémico
-
Se demostró que las enfermedad de la agalla de la corona es causada por a bacteria agrobacterium tumefaciens, la cual, transforma a las células vegetales normales en células tumorosas al introducir en ellas un plásmido propio
Want to make a timeline like this?
Use Timetoast to turn dates, events, milestones, and phases into a clear visual timeline you can build and share. Timetoast is a timeline maker for work, school, research, and stories.